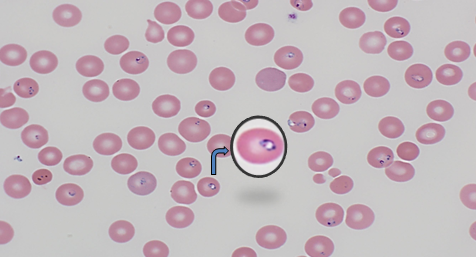

Babesia
3 lab findings of babesiosis
thrombocytopenia, hemolytic anemia, transaminitis
Tx for babesiosis
atovaquone + azithro
A’s and B’s
MAC should be tested for resistance to these drugs
MACrolides and amikacin
Consider adding _____ to azithro, rifampin, ethambutol for severe fibrocavitary MAC
amikacin
Preferred LTBI regimen for HIV+ pts
INH + rifapentine (or rifampin) x 3 mos
When to add steroids for PJP
A-a gradient >35 or PaO2 <70
immunoblasts, ↑hematocrit, ↓Plts; rash, pulm edema; Four Corners
Hantavirus cardiopulmonary syndrome
HUNTing is a blast!

eosinophilic intranuclear inclusion bodies (Cowdry bodies)

any of the Herpesviridae (HSV, CMV, or EBV)
Lab value elevated in PJP (other than beta-D-glucan)
LDH
NTM Dx requires 2 (+) sputum cultures or _____
1 (+) BAL culture
TB Tx for HIV+
RIPE x 8 weeks, then INH/RIF x 18 weeks
TB Tx for HIV+ unable to take PZA
RIE x 8 weeks, then INH/RIF x 31 weeks
stain used to see sulfur granules of Actinomyces
silver (GMS)

Leptospirosis


